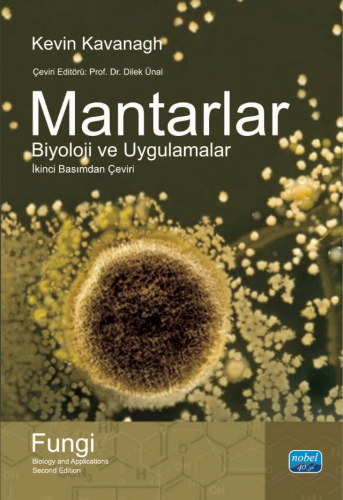
Üniversite Ders Kitapları, - Nobel Akademi - Mantarlar Biyoloji ve Uyg

Mantarlar Biyoloji ve Uygulamalar
Liste Fiyatı :
500,00TL
İndirimli Fiyat :
400,00TL
Kazancınız :
100,00TL
Taksitli fiyat :
3 x 133,33TL
Havale/EFT ile :
392,00TL
9786051339610
32775
https://www.pelikankitabevi.com.tr/universite-ders-kitaplari/nobel-akademi/mantarlar-biyoloji-ve-uygulamalar
Mantarlar Biyoloji ve Uygulamalar
400
Mantarlar: Biyoloji ve Uygulamalar kitabının ikinci basımı; biyokimya, genetik ve bu organizmalarının tıbbi ve ekonomik önemlerini kapsayan mantarların uygulamalarının kapsamlı tanıtımını sağlar. Daha önce bu konudaki bilgilerimizden farklı olarak, kısmen mantar fizyolojisi ve genetiğini de içeren, temel mantar biyolojisine geniş bakış açısında sunulan açılış bölümü ve aynı zamanda mantarların genomik uygulamaları üzerinde yeni bölüm içermektedir. Kitap daha sonra, mantarlardaki antibiyotik ve kimyasal bileşikler, mantar enzimler ve fungal proteomiklerinin biyoteknolojik kullanımı üzerine yeni bölümleri ve insanlardaki mantar hastalıkları, insanların tedavisinde kullanım için anti-fungal maddeler ve bitkilerin mantar patojenleri gibi konuları ayrıntılı kapsayarak devam eder.
Tamamı güncellenmiş ve Mantarların Genomik Uygulamaları, Mantar Enzimlerinin Biyoteknolojik Kullanımları ve Mantar Proteomikleri üzerine üç yeni bölüm eklenmiştir.
Gündelik hayatta tıbbi ve ekonomik önemi olan mantarların geniş kapsamlı uygulamalarına yer verilmiştir.
Mantar biyolojisi veya mikolojisi üzerine ilk dersi alan lisans öğrencileri için paha biçilmez bir kaynaktır.
Bu alanda uluslararası saygınlığı olan uzmanlar tarafından yazılmıştır. Renkli levha bölümü içermektedir.
- Açıklama
- Mantarlar: Biyoloji ve Uygulamalar kitabının ikinci basımı; biyokimya, genetik ve bu organizmalarının tıbbi ve ekonomik önemlerini kapsayan mantarların uygulamalarının kapsamlı tanıtımını sağlar. Daha önce bu konudaki bilgilerimizden farklı olarak, kısmen mantar fizyolojisi ve genetiğini de içeren, temel mantar biyolojisine geniş bakış açısında sunulan açılış bölümü ve aynı zamanda mantarların genomik uygulamaları üzerinde yeni bölüm içermektedir. Kitap daha sonra, mantarlardaki antibiyotik ve kimyasal bileşikler, mantar enzimler ve fungal proteomiklerinin biyoteknolojik kullanımı üzerine yeni bölümleri ve insanlardaki mantar hastalıkları, insanların tedavisinde kullanım için anti-fungal maddeler ve bitkilerin mantar patojenleri gibi konuları ayrıntılı kapsayarak devam eder.Tamamı güncellenmiş ve Mantarların Genomik Uygulamaları, Mantar Enzimlerinin Biyoteknolojik Kullanımları ve Mantar Proteomikleri üzerine üç yeni bölüm eklenmiştir.Gündelik hayatta tıbbi ve ekonomik önemi olan mantarların geniş kapsamlı uygulamalarına yer verilmiştir.Mantar biyolojisi veya mikolojisi üzerine ilk dersi alan lisans öğrencileri için paha biçilmez bir kaynaktır.Bu alanda uluslararası saygınlığı olan uzmanlar tarafından yazılmıştır. Renkli levha bölümü içermektedir.Stok Kodu:9786051339610Boyut:17x24Sayfa Sayısı:384Basım Yeri:AnkaraBasım Tarihi:2025 Mayıs
- Taksit Seçenekleri
- Axess KartlarTaksit SayısıTaksit tutarıGenel ToplamTek Çekim400,00400,002200,00400,003133,33400,00Ziraat BankkartTaksit SayısıTaksit tutarıGenel ToplamTek Çekim400,00400,002200,00400,003133,33400,00Maximum KartlarTaksit SayısıTaksit tutarıGenel ToplamTek Çekim400,00400,002200,00400,003133,33400,00Diğer KartlarTaksit SayısıTaksit tutarıGenel ToplamTek Çekim400,00400,002--3--
- Yorumlar
- Yorum yazBu kitabı henüz kimse eleştirmemiş.










